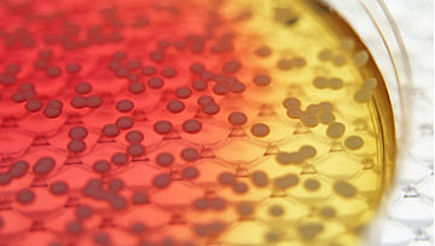

Infektion eller inflammation?
Infektion och inflammation är två ord som ofta kopplas samman. Trots att dessa ord ofta hör ihop så är de inte synonyma. Här på Infektionsguiden kan du lära dig mer om skillnaden.

Infektioner hos barn
Att undvika infektioner hos barn är nästintill omöjligt. Det är normalt att ett barn har mellan sex och åtta infektioner per år. Måste det vara så? Här på Infektionsguiden hittar du hygientips till dina barn.
Vad kan du om antibiotika?
Penicillin? Spektrum? Resistens? Vad kan du egentligen om antibiotika? Här får du chansen att testa dina kunskaper. Vi visar 10 påståenden, du svarar antingen Sant eller Falskt.